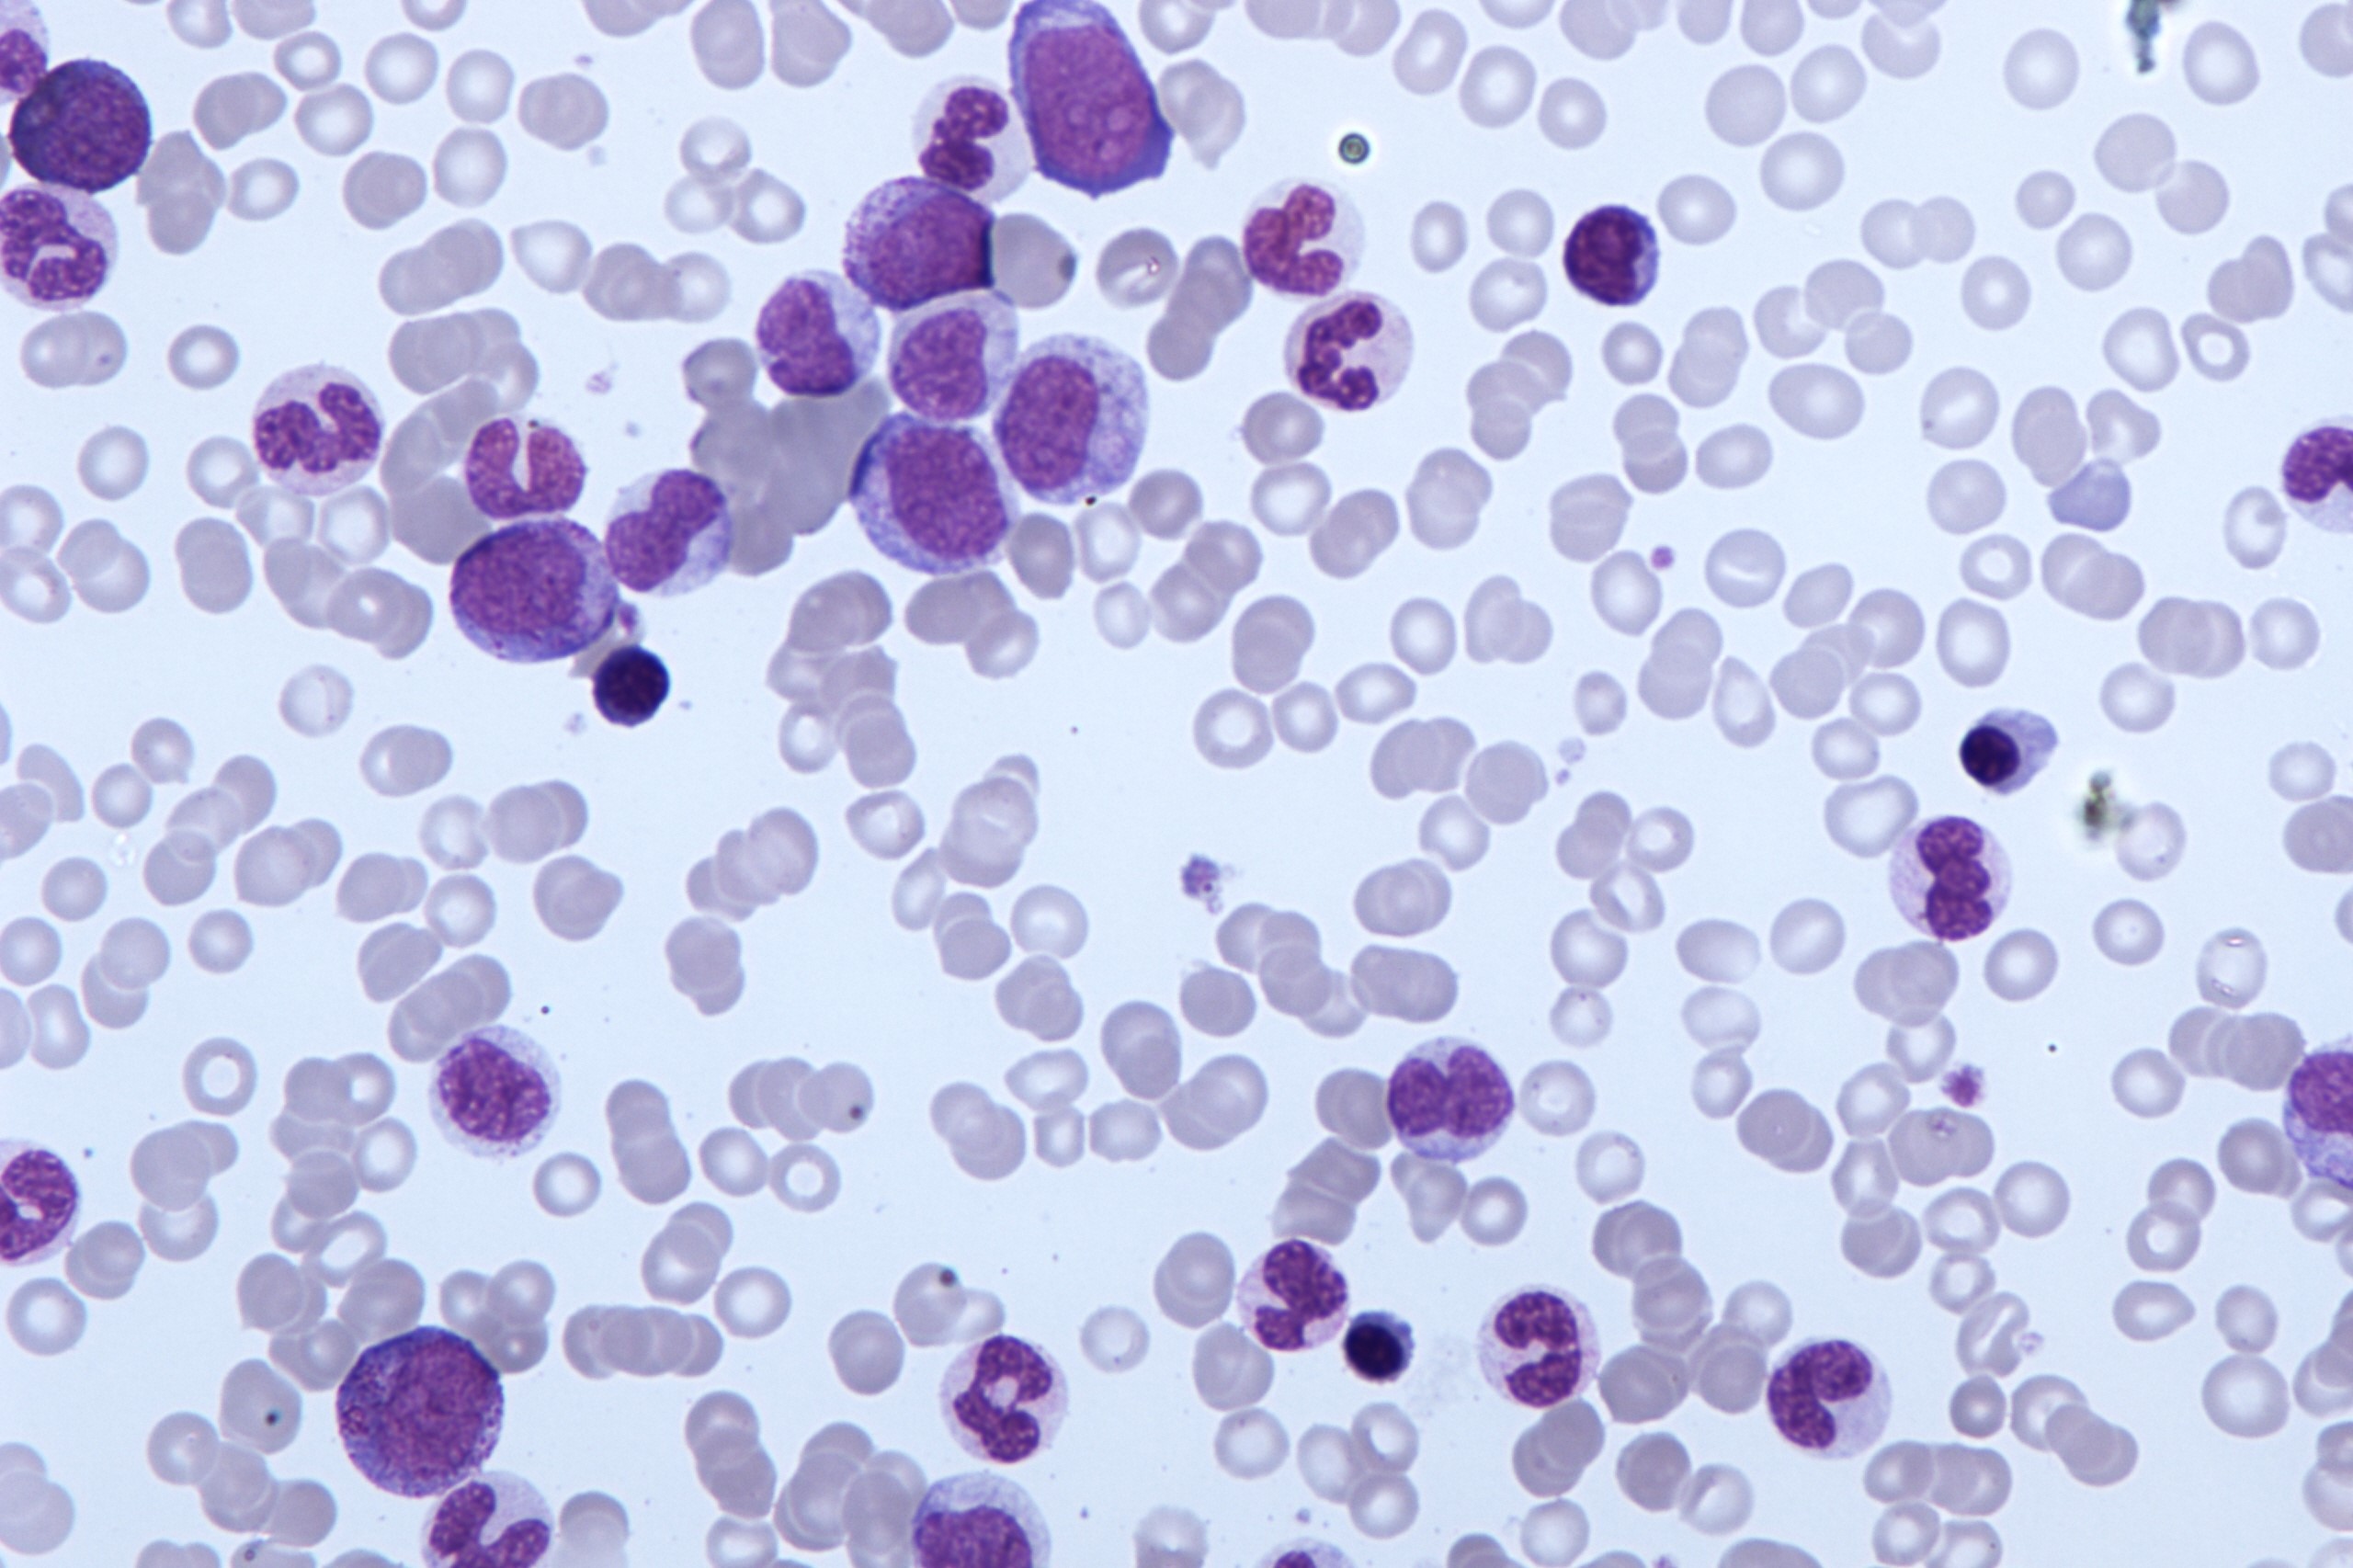

Στο ΠΑΣΟΚ δεν έχουν πάρει το μήνυμα ακόμα: Ή συνεργάζονται ή χάνονται...
ΣΥΜΒΑΙΝΕΙ ΤΩΡΑ
-
Ουκρανικά drones πλήττουν πάλι τη ρωσική ναυτική βάση στην Κροστάνδη! (βίντεο)
-
Oύτε Ουκρανία ούτε Σαουδική Αραβία: Το μικρό κράτος που θα αγοράσει αμερικανικά drones αξίας 2 δισ. δολαρίων
-
Βρέφος μόλις 7 μηνών σκοτώθηκε από πυρά Ισραηλινών στρατιωτών στη Δυτική Όχθη
-
Γ.Τσαγκαράκη: Το παιδικό τραύμα που η ηθοποιός δεν μπορεί να ξεχάσει με τίποτα – «Ακόμη το θυμάμαι» (βίντεο)
-
ΗΠΑ: 55χρονη είχε δεκάδες ερωτικές συνευρέσεις με 16χρονο μαθητή της – Δείτε τα μηνύματα που την «έκαψαν» (βίντεο)
-
Ν.Τραμπ για το Ιράν και το οπλοστάσιό του: «Τους έχουμε κάνει φοβερή ζημιά – Έχουν υποστεί ανεπανόρθωτα πλήγματα»
-
Όσιος Ιλαρίων ο Μέγας: Υπέστη τα πάνδεινα από τους Εικονομάχους και παρόλα αυτά δεν εγκατέλειψε την πίστη του!
-
«Μυστική» συνάντηση Β.Πούτιν και Γ.Σρέντερ στο Κρεμλίνο – Τι του ζήτησε ο Ρώσος πρόεδρος
-
Δείτε βίντεο: Σοκαριστική επίθεση 9 σκυλιών σε 11χρονο αγόρι στη Βραζιλία – Παραλίγο να τον κατασπαράξουν
-
Κλιμάκωση στον Κόλπο: Ισχυρές εκρήξεις σε Κουβέιτ & Μπαχρέιν μετά την εκτόξευση των Zolfaghar από το Ιράν (βίντεο)
Η χρόνια μυελομονοκυτταρική λευχαιμία (CMML) ξεκινά από κύτταρα στον μυελό των οστών και εισβάλλει στο αίμα.
Τα κύτταρα σχεδόν σε οποιοδήποτε μέρος του σώματος μπορούν να γίνουν καρκινικά και να εξαπλωθούν σε άλλες περιοχές του σώματος.
Χαρακτηριστικά της χρόνιας μυελομονοκυτταρικής λευχαιμίας
- Οι ασθενείς μπορεί να έχουν ελλείψεις σε ορισμένα αιμοσφαίρια, αλλά ένα κύριο πρόβλημα είναι τα πάρα πολλά μονοκύτταρα. Συχνά, ο αριθμός των μονοκυττάρων είναι πολύ υψηλότερος, με αποτέλεσμα ο συνολικός αριθμός των λευκών αιμοσφαιρίων τους να γίνει επίσης πολύ υψηλός.
- Συνήθως υπάρχουν κάποια μη φυσιολογικά κύτταρα (βλάστες) στον μυελό των οστών. Η ποσότητα των βλαστών κατά την μυελομονοκυτταρική λευχαιμία είναι κάτω από 20%.
- Πολλά άτομα με μυελομονοκυτταρική λευχαιμία έχουν διευρυμένους σπλήνες.
- Περίπου το 15-30% των ατόμων με μυελομονοκυτταρική λευχαιμία αναπτύσσουν οξεία μυελογενή λευχαιμία.
Δεδομένου ότι νόσος έχει χαρακτηριστικά τόσο μυελοδυσπλαστικού συνδρόμου όσο και μυελοπολλαπλασιαστικού νεοπλάσματος, οι ειδικοί δημιούργησαν μια νέα κατηγορία για αυτό: μυελοδυσπλαστικό/μυελοπολλαπλασιαστικό νεόπλασμα. Η μυελομονοκυτταρική λευχαιμία είναι η πιο κοινή ασθένεια αυτής της ομάδας. Πολύ λιγότερο κοινές ασθένειες αυτής της ομάδας είναι η άτυπη χρόνια μυελογενής λευχαιμία και η νεανική μυελομονοκυτταρική λευχαιμία. Σε όλες αυτές τις ασθένειες παράγονται πολλά μη φυσιολογικά αιμοσφαίρια.
Η χρόνια μυελοειδής λευχαιμία είναι ένα παράδειγμα μυελοϋπερπλαστικού νεοπλάσματος όπου υπάρχει υπερπαραγωγή λευκών αιμοσφαιρίων.
Χρόνια μυελομονοκυτταρική λευχαιμία: Σημάδια και συμπτώματα
Το πιο κοινό σημάδι είναι η ύπαρξη υπερβολικά πολλών μονοκυττάρων (που φαίνεται σε μια εξέταση αίματος).
Η ύπαρξη πάρα πολλών μονοκυττάρων προκαλεί επίσης πολλά από τα συμπτώματα της CMML. Αυτά τα μονοκύτταρα μπορούν να εγκατασταθούν στον σπλήνα ή στο ήπαρ, διευρύνοντας αυτά τα όργανα. Ένας διογκωμένος σπλήνας (σπληνομεγαλία) μπορεί να προκαλέσει πόνο στο άνω αριστερό μέρος της κοιλιάς. Μπορεί επίσης να κάνει τους ασθενείς να αισθάνονται χορτάτοι πολύ γρήγορα όταν τρώνε. Εάν το ήπαρ γίνει πολύ μεγάλο (ηπατομεγαλία), προκαλεί ενόχληση στο άνω δεξί μέρος της κοιλιάς.
Ο χαμηλός αριθμός άλλων τύπων αιμοσφαιρίων προκαλεί πολλά από τα σημάδια και συμπτώματα της CMML:
- Έλλειψη ερυθρών αιμοσφαιρίων (αναιμία) που οδηγεί σε αίσθημα ακραίας κούρασης, με δύσπνοια και χλωμό δέρμα.
- Έλλειψη αρκετών φυσιολογικών λευκών αιμοσφαιρίων (λευκοπενία) που οδηγεί σε συχνές ή σοβαρές λοιμώξεις.
- Έλλειψη αιμοπεταλίων (θρομβοπενία) που οδηγεί σε εύκολους μώλωπες και αιμορραγία. Μερικοί άνθρωποι παρατηρούν συχνές ή σοβαρές ρινορραγίες ή αιμορραγία από τα ούλα τους.
Άλλα συμπτώματα μπορεί να περιλαμβάνουν απώλεια βάρους, πυρετό και απώλεια όρεξης. Φυσικά, πολλά από αυτά τα προβλήματα προκαλούνται συχνότερα από κάτι άλλο εκτός από τον καρκίνο. Εάν έχετε συμπτώματα, θα πρέπει να επισκεφτείτε έναν γιατρό για να βρεθεί η αιτία.





























Tο pronews.gr δημοσιεύει κάθε σχόλιο το οποίο είναι σχετικό με το θέμα στο οποίο αναφέρεται το άρθρο. Ο καθένας έχει το δικαίωμα να εκφράζει ελεύθερα τις απόψεις του. Ωστόσο, αυτό δεν σημαίνει ότι υιοθετούμε τις απόψεις αυτές και διατηρούμε το δικαίωμα να μην δημοσιεύουμε συκοφαντικά ή υβριστικά σχόλια όπου τα εντοπίζουμε. Σε κάθε περίπτωση ο καθένας φέρει την ευθύνη των όσων γράφει και το pronews.gr ουδεμία νομική ή άλλα ευθύνη φέρει.
Δικαίωμα συμμετοχής στη συζήτηση έχουν μόνο όσοι έχουν επιβεβαιώσει το email τους στην υπηρεσία disqus. Εάν δεν έχετε ήδη επιβεβαιώσει το email σας, μπορείτε να ζητήσετε να σας αποσταλεί νέο email επιβεβαίωσης από το disqus.com
Όποιος χρήστης της πλατφόρμας του disqus.com ενδιαφέρεται να αναλάβει διαχείριση (moderating) των σχολίων στα άρθρα του pronews.gr σε εθελοντική βάση, μπορεί να στείλει τα στοιχεία του και στοιχεία επικοινωνίας στο info3@pronews.gr και θα εξεταστεί άμεσα η υποψηφιότητά του.